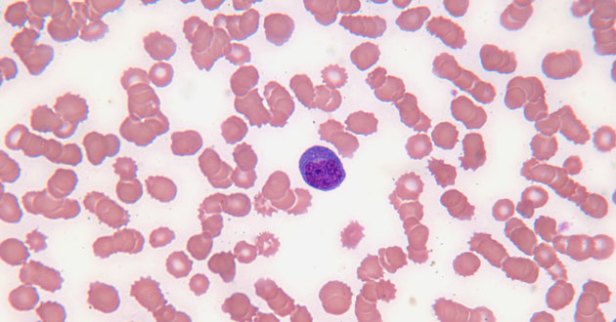

México, DF.- Científicos de la Universidad de Medicina Veterinaria de Viena, descubrieron el origen de la leucemia lo que, afirman, tendrá “consecuencias importantes” para el tratamiento de este padecimiento.
México, DF.- Científicos de la Universidad de Medicina Veterinaria de Viena, descubrieron el origen de la leucemia lo que, afirman, tendrá “consecuencias importantes” para el tratamiento de este padecimiento.
Las diversas variedades de leucemia LMC y B-LLA se forman a partir de una célula predecesora común, aseguraron los expertos de las Facultades de Genética y Cría de Animales, y de Toxicología y Farmacología, bajo la dirección de Boris Kovacic.
La universidad agrega que las bases de algunas hipótesis vigentes de la leucemia son cuestionadas, por lo que el hallazgo “tiene consecuencias extremadamente importantes para el tratamiento de una forma especialmente agresiva” de esta enfermedad.
Muchos tipos de cáncer se forman por mutaciones de las células del organismo. Hasta ahora se suponía que el estado de diferenciación de dichas células determina qué tipo específico de cáncer se desarrolla.
Así, por ejemplo, la llamada leucemia mieloide crónica (LMC) se desarrollaría a partir de células madre de la médula ósea, mientras que las células precursoras de linfocitos B estarían en el origen de la leucemia linfoblástica aguda de células B (B-LLA).
Pero el equipo de Kovacic asegura haber demostrado que ambas variedades de la enfermedad se desarrollan a partir de células hematopoyéticas madre.
Según Kovacic, el descubrimiento revela que una terapia que ataca todas las células cancerígenas de una sola manera «no puede funcionar».
FUENTE: AZTECA NOTICIAS


